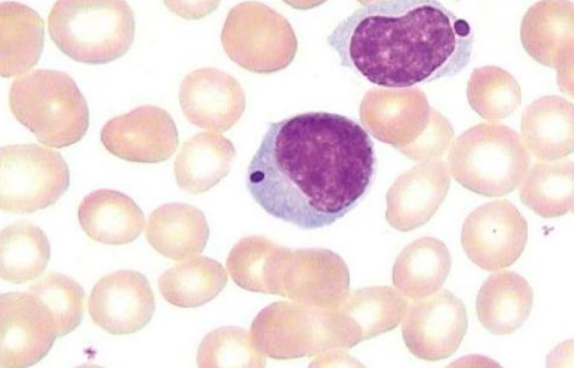

【资讯导读】从原来治疗方案到用威托克治疗的数据分析。中位间隔时间为30天(0.5-9)。中位剂量为400mg(100-1200),57%的患者达到目标剂量。10例患者(29%)治疗过程中需减少威托克的剂量,10例患
从原来治疗方案到用威托克治疗的数据分析。中位间隔时间为30天(0.5-9)。中位剂量为400mg(100-1200),57%的患者达到目标剂量。10例患者(29%)治疗过程中需减少威托克的剂量,10例患者(29%)在治疗过程被迫中断威托克治疗,停用威托克的中位时间为13天(7-46),造成药物中断和剂量减少的最常见原因是中性粒细胞减少和血小板减少。
就生存预后而言,总缓解率为26%(n=9;N=1CR),35%(n=12)是稳定的。中位PFS为2个月,中位OS为4.5个月。停止性病最常见的原因是疾病进展(n=21.62%),其次是毒副作用(n=4.12%)。
组织病理学分析显示,浸润性B细胞淋巴瘤(HGBL/德国淋巴细胞白血病、逆转录病毒病、PTLD淋巴瘤、转移淋巴结淋巴瘤)的中位全功能评分为2个月,而全功能评分为3个月。然而,MCL患者的PFS和OS为6个月。惰性非霍奇金淋巴瘤(MZL,FL)的中值PFS为2个月,OS为5个月。
威托克药品详细信息请进入:https://www.inmedf.com/zhongliu/bxb/20201419.html